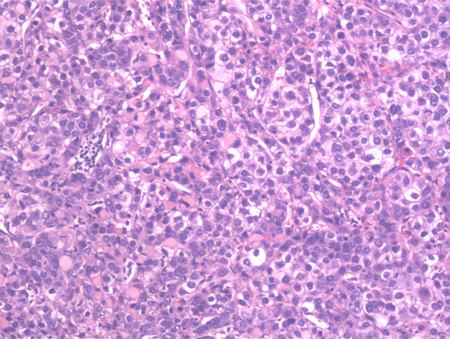

Investigations
1st investigations to order
full blood count
Test
Patients with low mean corpuscular volume (MCV) and low haemoglobin may have possible variceal bleeding. However, high MCV can be seen in patients with HCC due to alcohol-related cirrhosis.
Low platelet count is indicative of portal hypertension resulting from cirrhosis.
Result
microcytic anaemia and/or thrombocytopenia
basic metabolic panel
Test
Patients may have hyponatraemia due to volume overload or diuretic use.
Urea can be elevated secondary to prerenal azotaemia, acute renal insufficiency, chronic renal insufficiency, or hepatorenal syndrome.
Result
hyponatraemia; high urea
liver function tests
Test
Can be used initially to measure the severity of liver disease.
Transaminases, alkaline phosphatase, and bilirubin are elevated in conjunction with low albumin due to chronic liver disease and cirrhosis.
Good liver functional status is required for tumour resection, thereby preventing decompensation of liver or liver failure after resection.
Result
elevated aminotransferases, alkaline phosphatase, and bilirubin; low albumin
prothrombin time/INR
Test
Measures the synthetic function of the liver. It is helpful to determine the synthetic functional capacity of the liver if a patient is a candidate for liver resection or liver transplantation.
Result
normal or elevated
viral hepatitis panel
Test
Determines a viral cause (hepatitis B and C) of cirrhosis resulting in HCC.
Result
may be positive
alpha fetoprotein (AFP)
Test
Serum AFP levels can be helpful, although they are elevated in only 60% of patients with HCC (typically those with the most advanced disease), hence a normal AFP level does not rule out HCC.[60] Further, elevated AFP levels can also occur in, for example, intrahepatic cholangiocarcinoma, gastric cancer, and germ cell tumours.[3] A rise in serum AFP in a patient with cirrhosis should raise the suspicion for HCC. Mild elevations may occur in patients with chronic hepatitis without HCC. Sensitivity ranges from 41% to 65%, and specificity ranges from 80% to 94%.[61] Specificity increases with higher AFP levels.[62] AFP may be used in conjunction with abdominal ultrasound when screening for HCC.
Result
may be elevated
ultrasound of liver
Test
An initial imaging test for any patients with cirrhosis to screen for HCC. It is widely available and non-invasive.
Abdominal ultrasounds are routinely ordered at 6-month intervals to screen for HCC in high-risk people. If the initial result demonstrates a lesion of <1 cm, then follow-up at 3- to 4-month intervals is recommended. If there is no growth over 1-2 years, routine 6-monthly surveillance can be continued.
The sensitivity of ultrasound for HCC detection is 60% and the specificity 97%.[66]
Result
poorly defined margins and coarse, irregular internal echoes
Investigations to consider
contrast CT scan of abdomen
Test
Triphasic contrast CT scan is superior to ultrasound of the liver.[67] It is highly specific for HCC.
If there is an elevated AFP and/or abnormal ultrasound with focal liver lesion(s), then 4-phase multidetector CT or contrast magnetic resonance imaging of the abdomen should be ordered to confirm the diagnosis of HCC.[3] The National Comprehensive Cancer Network (NCCN) suggests liver dynamic CT or dynamic MRI as an alternative to ultrasound if ultrasound is unable to detect nodules or if visualisation is poor.[64]
Result
typical hypervascular pattern
contrast MRI of abdomen
Test
If there is elevated AFP and/or abnormal ultrasound with focal liver lesion(s), then 4-phase multidetector CT or contrast MRI of the abdomen should be ordered to confirm the diagnosis of HCC.[3][Figure caption and citation for the preceding image starts]: MRI: hypervascularity on the arterial phaseFrom the personal collection of Badar Muneer MD, Florida Hospital Transplant Center, Orlando, FL; used with permission [Citation ends].
[Figure caption and citation for the preceding image starts]: MRI: washout portal phaseFrom the personal collection of Badar Muneer MD, Florida Hospital Transplant Center, Orlando, FL; used with permission [Citation ends].
[Figure caption and citation for the preceding image starts]: MRI: following transarterial chemo-embolisation treatmentFrom the personal collection of Badar Muneer MD, Florida Hospital Transplant Center, Orlando, FL; used with permission [Citation ends].
The National Comprehensive Cancer Network (NCCN) suggests liver dynamic CT or dynamic MRI as an alternative to ultrasound if ultrasound is unable to detect nodules or if visualisation is poor.[64] The sensitivity and specificity of MRI of the abdomen are 81% and 85%, respectively, compared with 68% and 93% for CT scans of the abdomen.[66]
MRI is superior to CT scan of the abdomen in differentiating dysplastic nodules, vascular lesions (haemangioma), and focal fat from HCC. However, one Cochrane review found that MRI may miss up to 16% of people with HCC, and 6% of patients without HCC may be treated unnecessarily.[65]
[
]
MRI is typically less readily available than CT.
Result
high-intensity pattern on T2-weighted images and a low-intensity pattern on T1-weighted images on MRI
liver biopsy
Test
Most of the time, the diagnosis of HCC can be made radiologically in patients with cirrhosis without the need for liver biopsy. However, biopsy should be considered if the lesion remains indeterminate and in order to establish diagnosis of HCC in patients without cirrhosis or chronic hepatitis B virus infection.[3]
An ultrasound-guided percutaneous liver biopsy is favoured.[Figure caption and citation for the preceding image starts]: Medium power microscopic view of a haematoxylin and eosin stained section depicting normal liver on the right and HCC on the left. A sharp boundary separates the distinct zones of normal liver and tumourFrom the personal collection of Badar Muneer MD, Florida Hospital Transplant Center, Orlando, FL; used with permission [Citation ends].
[Figure caption and citation for the preceding image starts]: High-power view of haematoxylin and eosin stained section of a well-differentiated HCC. Predominantly a solid pattern of growth with some nesting of malignant cells, separated by compressed sinusoids; some cells have clearing of the cytoplasmFrom the personal collection of Badar Muneer MD, Florida Hospital Transplant Center, Orlando, FL; used with permission [Citation ends].
Core needle biopsy may be considered in certain clinical scenarios.[64]
Biopsy of liver lesions may also be necessary if clinical features suggest the possibility of metastatic liver disease or cholangiocarcinoma.
Result
well-differentiated to poorly differentiated hepatocytes with large multinucleated giant cells having central necrosis
computed tomography scan of chest
Test
Can rule out metastatic HCC.
Result
enhancing nodule or mass in the lungs is suggestive of metastatic lesion from HCC
bone scan
Test
Can be used to evaluate bone metastasis.
In general, increased activity or hot spots are not necessarily metastases. This finding should be correlated clinically.
Result
evidence of 'hot' spots
Use of this content is subject to our disclaimer